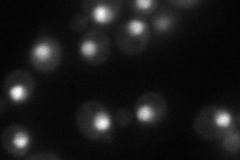
YBL006C
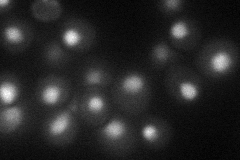
YBL006C
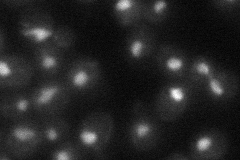
YBL006C
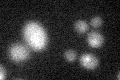
YBL006C
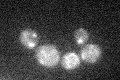
YBL006C
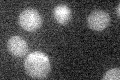
YBL006C

View description
Component of the RSC chromatin remodeling complex; interacts with Rsc3p, Rsc30p, Npl6p, and Htl1p to form a module important for a broad range of RSC functions
Localization:
Intensity:
Fold change:
Significance:
-
C’ GFP library in SD

below threshold16.76 -
N' NOP1pr-GFP in SD
nucleus64.4612 -
N' TEF2pr-mCherry in SD
nucleus38.0029 -
N' NATIVEpr-GFP in SD
nucleus38.9343 -
N' TEF2pr-VC and Cyto-VN in SD

nucleus29.1099 -
C’ GFP library in SD+DTT
cytosol16.841No -
C’ GFP library in SD+H2O2
cytosol16.991.01No -
C’ GFP library in Starvation Media
cytosol16.730.99No -
C’ GFP library on the background of Pup2-DaMP

below threshold -
C’ GFP library on the background of CCT mutant

below threshold14.67340.875183No
